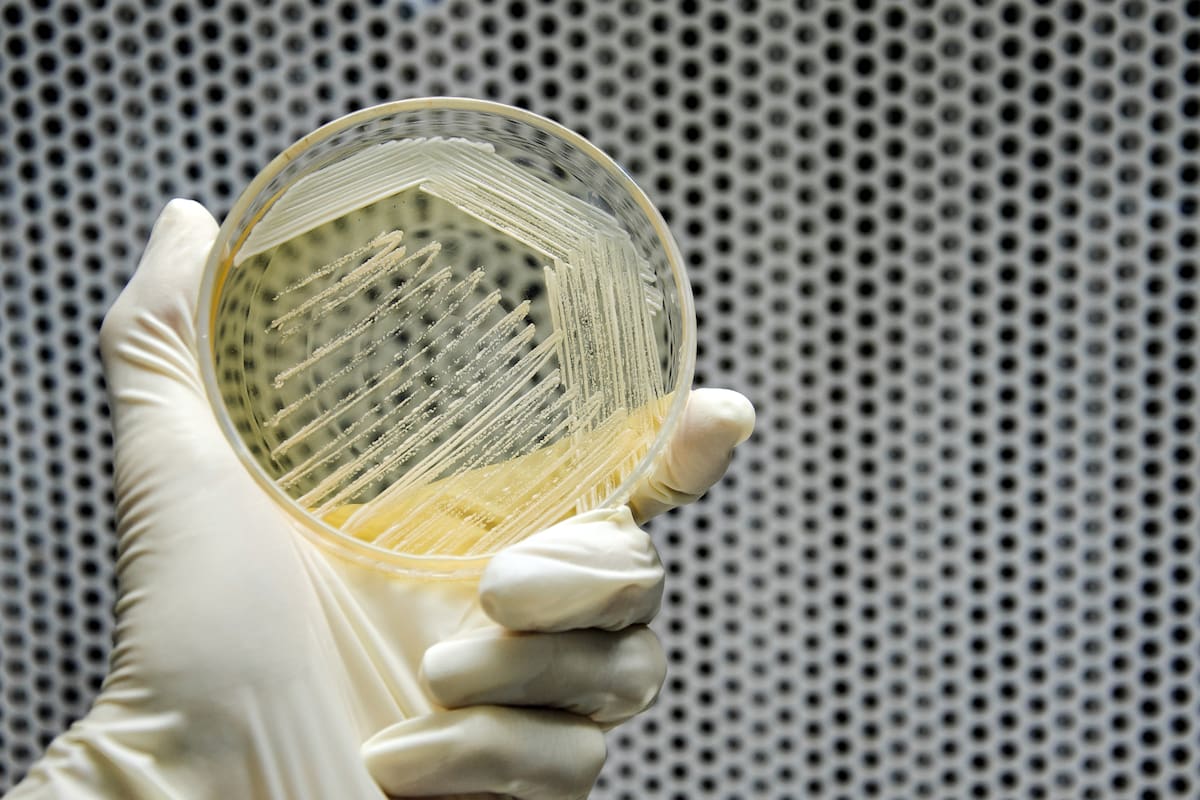
Una placa petri con muestras de "Saccharomyces cerevisiae"

¿Se puede demorar el envejecimiento? Las claves para alargar la vida se esconden en el microbio que produce la cerveza o el vino
Un experimento logra incrementar en un 80% la duración de la vida de la levadura ‘Saccharomyces cerevisiae’ empleando técnicas de biología sintética
6 minutos de lectura'
MADRID.- Thomas Johnson demostró hace más de tres décadas que la modificación de un solo gen —el age-1— incrementaba la vida de gusanos C. elegans hasta un 60%. Pese a la enorme distancia evolutiva que nos separa de ellos, los mecanismos útiles para la supervivencia saltan de rama en rama del árbol de la vida y se conservan en los genomas de multitud de especies, incluidos los humanos. Lo que funciona en un gusano o un ratón, o incluso en una levadura, no tiene por qué no funcionar también en nosotros. Pero los resultados manipulando la esperanza de vida de estos parientes remotos alienta la búsqueda de modificaciones genéticas en busca de una juventud menos breve.
Hace tres años, un grupo de investigadores de la Universidad de California en San Diego (UCSD) encontró un mecanismo esencial en el proceso de envejecimiento de un hongo unicelular que nos acompaña, al menos, desde el origen de la civilización. La levadura Saccharomyces cerevisiae, con la que se hace pan, cerveza o vino, sigue una de dos direcciones en su camino hacia la muerte. La mitad de estas células envejecen cuando su ADN pierde estabilidad; y la otra mitad, con el deterioro de las mitocondrias, una estructura que proporciona energía a la célula. Pero no se estropean de las dos formas a la vez.
Los mismos investigadores de la UCSD, liderados por Nan Hao, explican ahora en un artículo que publica la revista Science cómo han creado una especie de interruptor que, manipulando dos reguladores de la actividad de los genes, cambia el sentido del envejecimiento celular. Del deterioro del ADN al de las mitocondrias y viceversa, ese mecanismo mantiene a las células de la levadura de la cerveza en un equilibrio entre sus rutas hacia el ocaso. De un modo parecido a un termostato, en el que cuando se alcanza una temperatura superior se enciende el refrigerador y cuando se llega a un límite inferior se introduce calor, aquí se aplica la biología sintética para introducir un sistema similar. Con lo que se conoce como oscilador genético, las células cambian su forma de envejecer cuando han avanzado demasiado en uno de los dos sentidos. Con este juego de equilibrios, han prolongado su existencia hasta un 80%, un nuevo récord mundial de la biología, y los investigadores plantean que este tipo de osciladores podrían servir para ralentizar el camino hacia la muerte que comienza cada vez que aparece una célula. También las del cuerpo humano.
Ralentizar el envejecimiento
Ahora los autores pretenden “identificar los circuitos genéticos regulatorios subyacentes al envejecimiento en varios tipos de células humanas y aplicar esta estrategia de ingeniería para modificarlas y ralentizar su envejecimiento”, explica Nan Hao, autor principal del estudio y codirector del Instituto de Biología Sintética de la UCSD. “Si funciona, intentaremos hacer lo mismo en células dentro de animales vivos, como ratones”, añade. Hao reconoce que la ingeniería genética “requiere más tiempo en las células humanas y los circuitos que regulan los genes son, a menudo, más complicados”, continúa. “Necesitaremos más tiempo y recursos para probar estas ideas y estrategias, pero no creo que haya nada fundamental que nos impida hacerlo”, concluye.
Carlos López Otín, investigador de la Universidad de Oviedo y experto en envejecimiento, reconoce el valor del estudio de estos investigadores que, como otros antes, han utilizado “modelos simples para tratar de entender la colosal y fascinante complejidad de la vida”. “Puede parecer extraño que de un organismo unicelular podamos aprender lecciones sobre el efecto del paso del tiempo en nuestros cuerpos formados por muchos billones de células de más de 200 tipos distintos. Pero, no debemos olvidar una frase mítica del gran Jacques Monod, Nobel de Medicina por descubrir las primeras claves de la regulación génica en bacterias: ‘Lo que es válido para una bacteria, lo es también para un elefante”, continúa. “Sin embargo, —cuestiona—, su extrapolación a células humanas y a nuestra vida cotidiana parece todavía lejana”.
“Los organismos unicelulares [como la levadura empleada en este experimento] son naturalmente egoístas, su principal objetivo es dividirse: el sueño de una bacteria o de una levadura es crear otras iguales que ellas”, explica López Otín. Este “egoísmo celular es un propósito que nuestras altruistas y solidarias células rechazan” y solo lo adoptan si al acumular daños moleculares se transforman y se convierten en tumorales. “Por eso, en humanos no es suficiente con evitar a toda costa que las células envejezcan y se logre extender la longevidad. El precio de estas estrategias tan publicitadas y anheladas por algunos puede ser el desarrollo de graves patologías, incluyendo tumores malignos, capaces de adelgazar la longevidad humana de manera muy considerable”, prosigue López Otín.
Para el científico, la pregunta que surge ante estos resultados es: si la evolución podía haber creado un oscilador semejante al creado por estos autores modificando solo dos genes, ¿por qué no ha sucedido desde la aparición de la vida hace más de 3.500 millones de años? Para entender el motivo de esta carencia y comprender los costes de extender la longevidad, López Otín propone realizar un experimento en el que se permitiera competir a las levaduras portadoras de los genes modificados con las correspondientes levaduras normales “para analizar si alguna de las cepas se impone selectivamente con el paso del tiempo en distintas condiciones”. Además, plantea crear otros tipos de osciladores, no para extender innecesariamente la longevidad, sino con el afán de mantener la homeostasis, nuestro imprescindible equilibrio interno. “Ello podría contribuir a mejorar nuestra salud, algo que me parece un propósito más sensato y asequible que aspirar a improbables sueños de inmortalidad”, concluye.
Para Jordi García Ojalvo, investigador de la Universitat Pompeu Fabra de Barcelona y colaborador de Michael Elowitz, creador del primer oscilador genético sintético, cree que, “más allá de las aplicaciones que puedan tener los resultados de este estudio, que podrían llegar dentro de muchos años, lo más interesante es que demuestra cómo la biología sintética se puede utilizar para entender cómo funcionan y cómo envejecen los organismos, nos ayuda a ir al límite en ese conocimiento”. “El envejecimiento en células humanas o en un organismo completo es muy complicado, pero todas las células de la Tierra tienen 20 aminoácidos y los mismos cuatro ácidos nucleicos”, añade. “Lo que aprendamos de estas células, además de muy interesante, podrá ser útil para buscar aplicaciones muchos años después”, resume.
Por Daniel Mediavilla
©EL PAÍS, SL
1Murió el niño de un año que estaba internado en Mendoza con lesiones cerebrales
2Previo a la exhibición de Franco Colapinto, vecinos y comerciantes entre la expectativa y las quejas por la falta de información
3La psicología dice que venimos al mundo a desarmar lo que nos enseñaron y a aprender cosas nuevas
4Hay alerta amarilla por vientos, tormentas y nevadas para este sábado 25 de abril: las provincias afectadas





